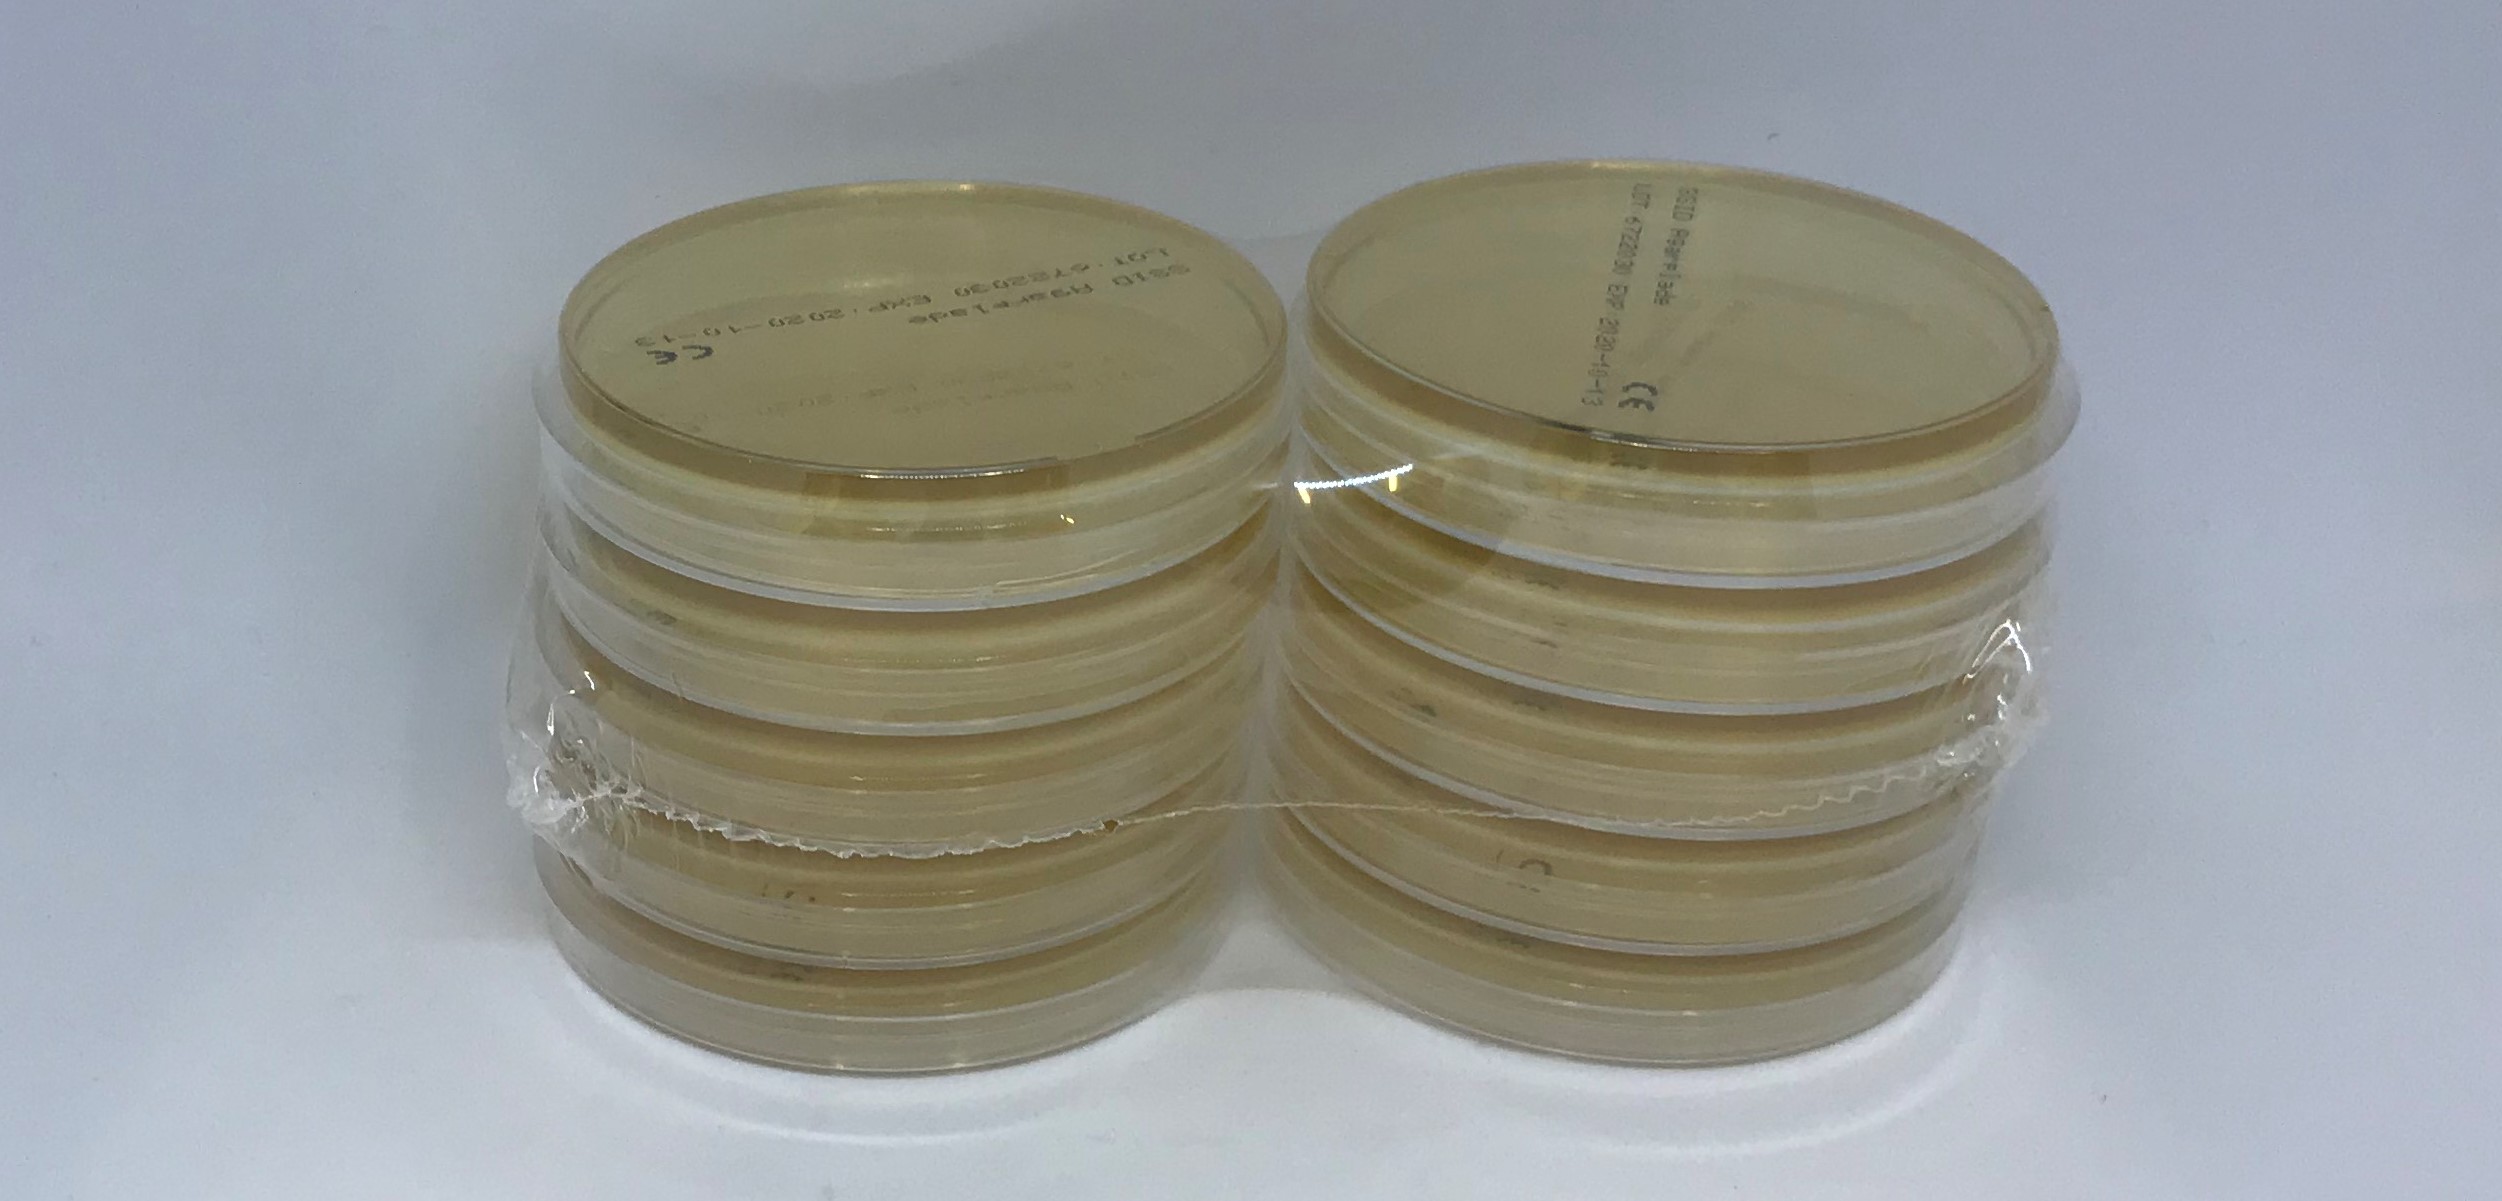
672 Agarplade, 9 cm 10 stk
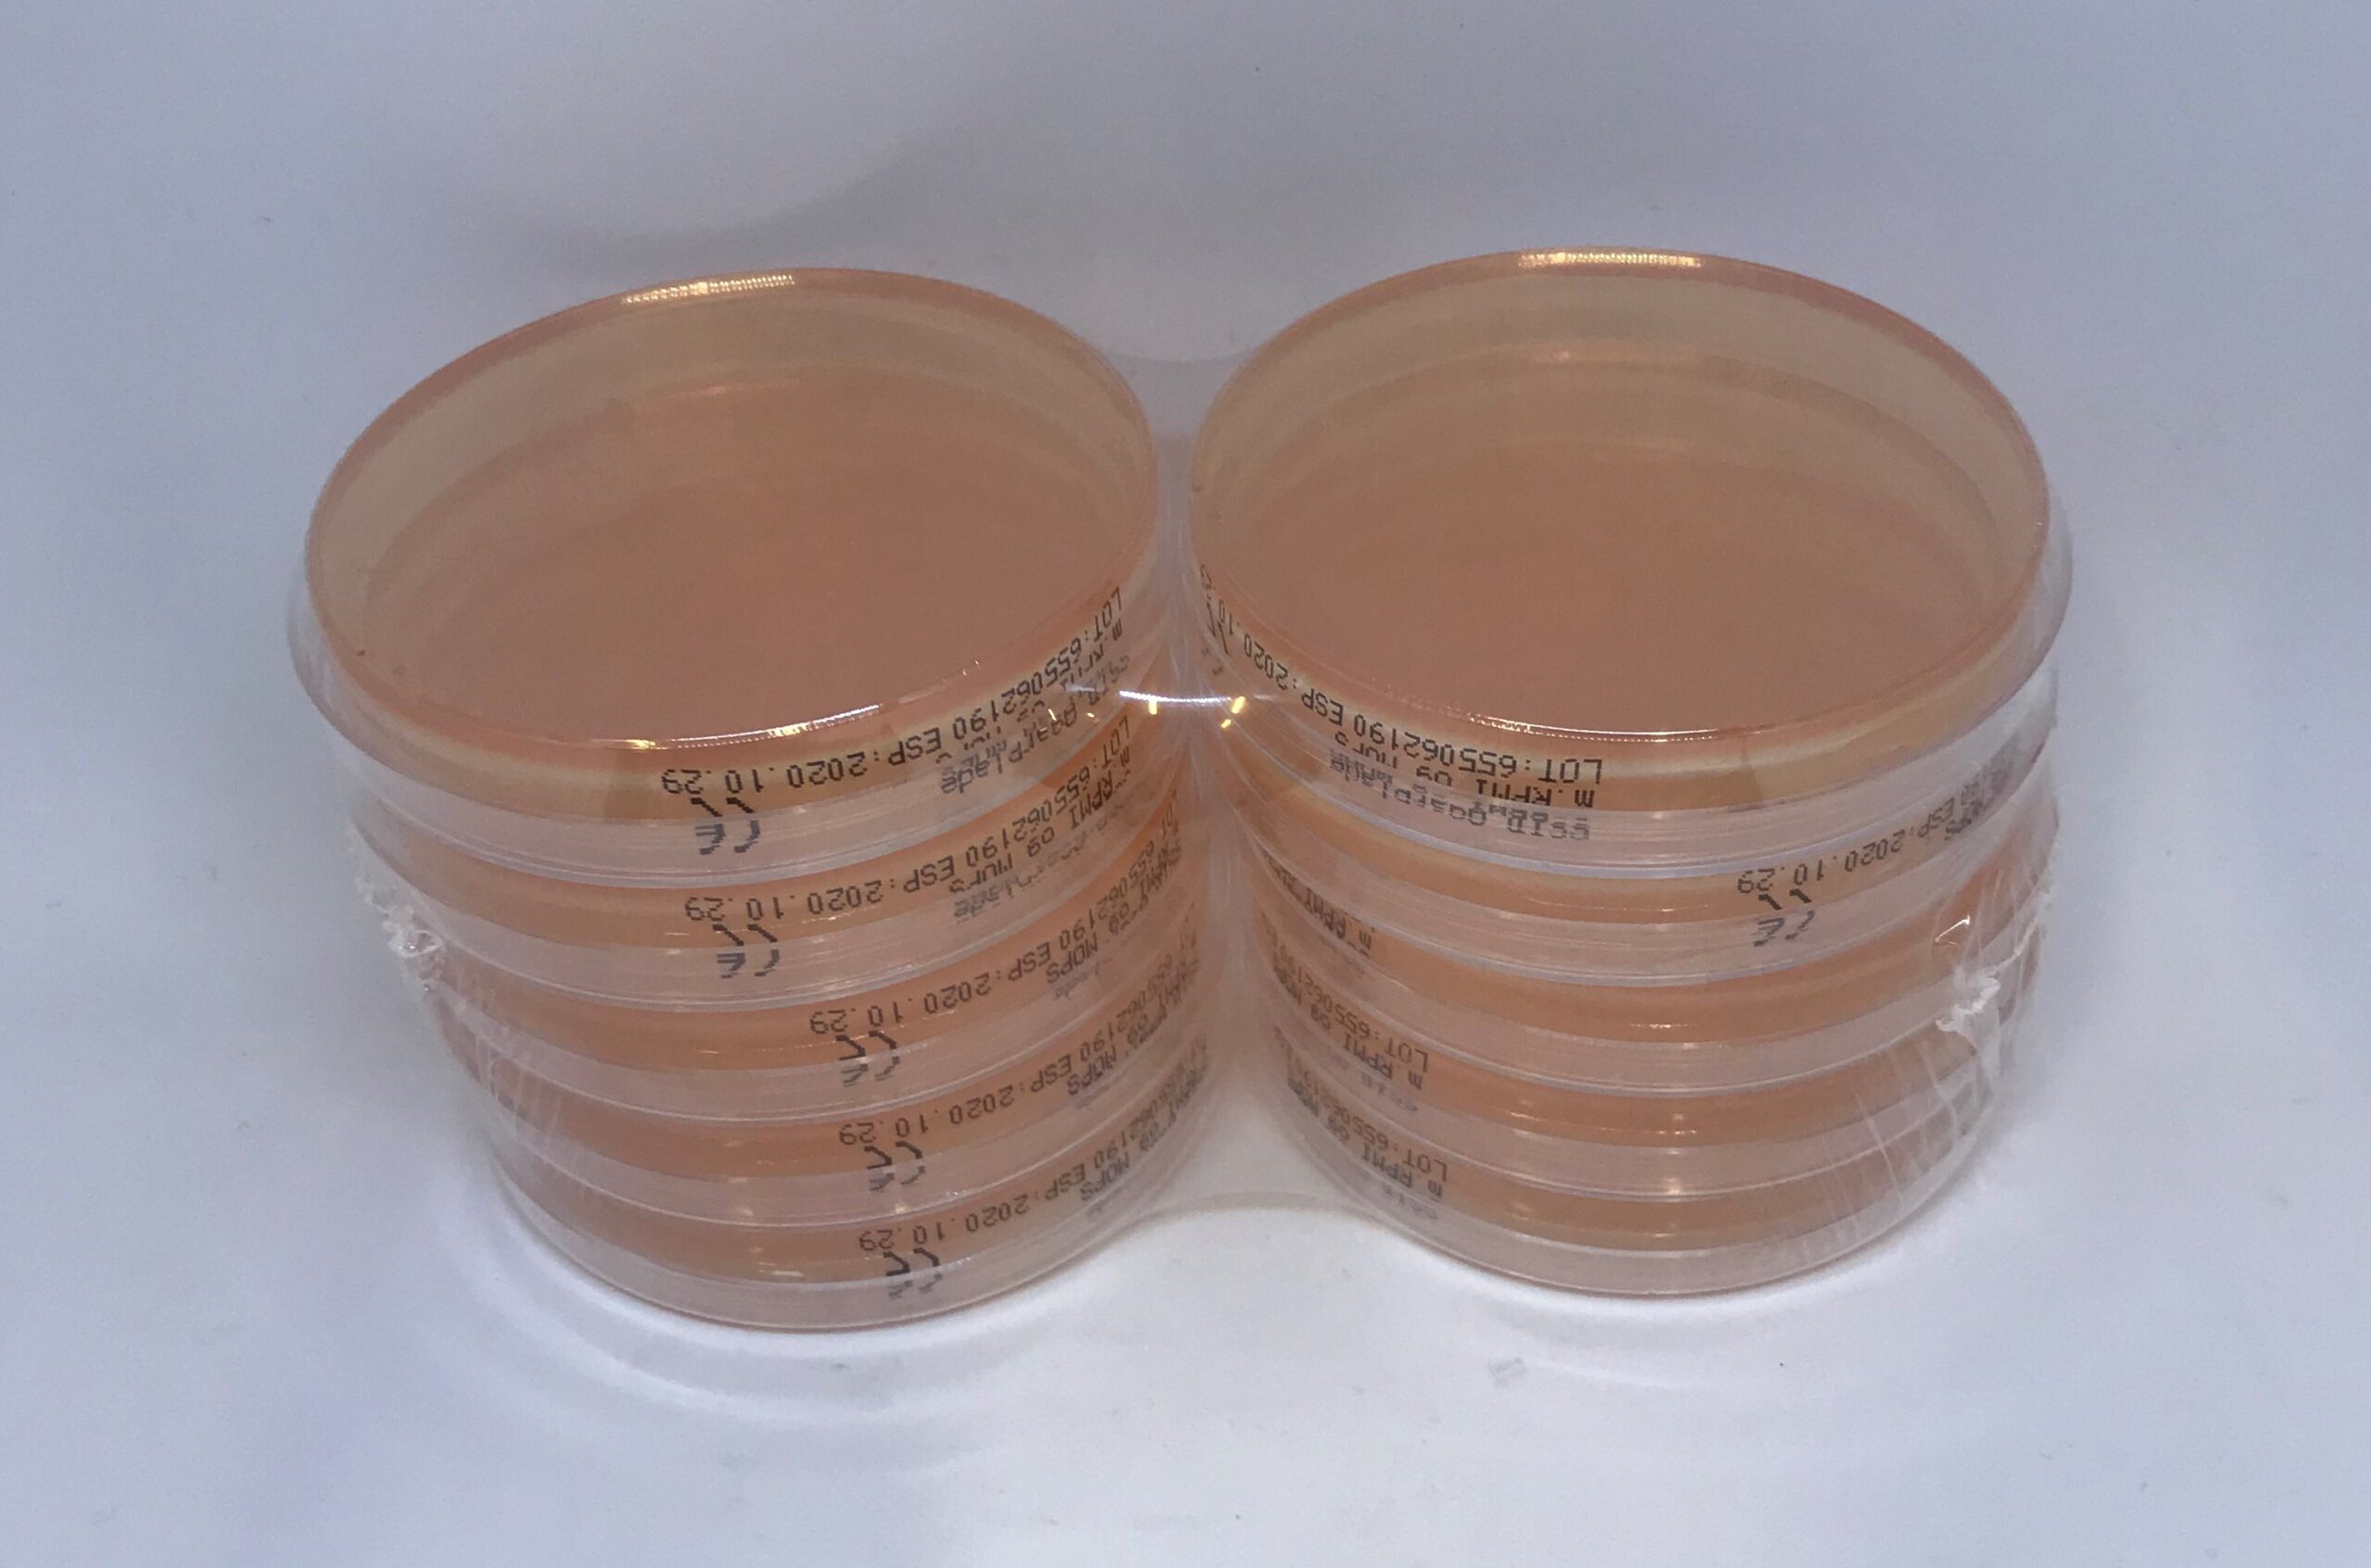
65506 Agarplade m. RPMI og MOPS, 9 cm 10 stk
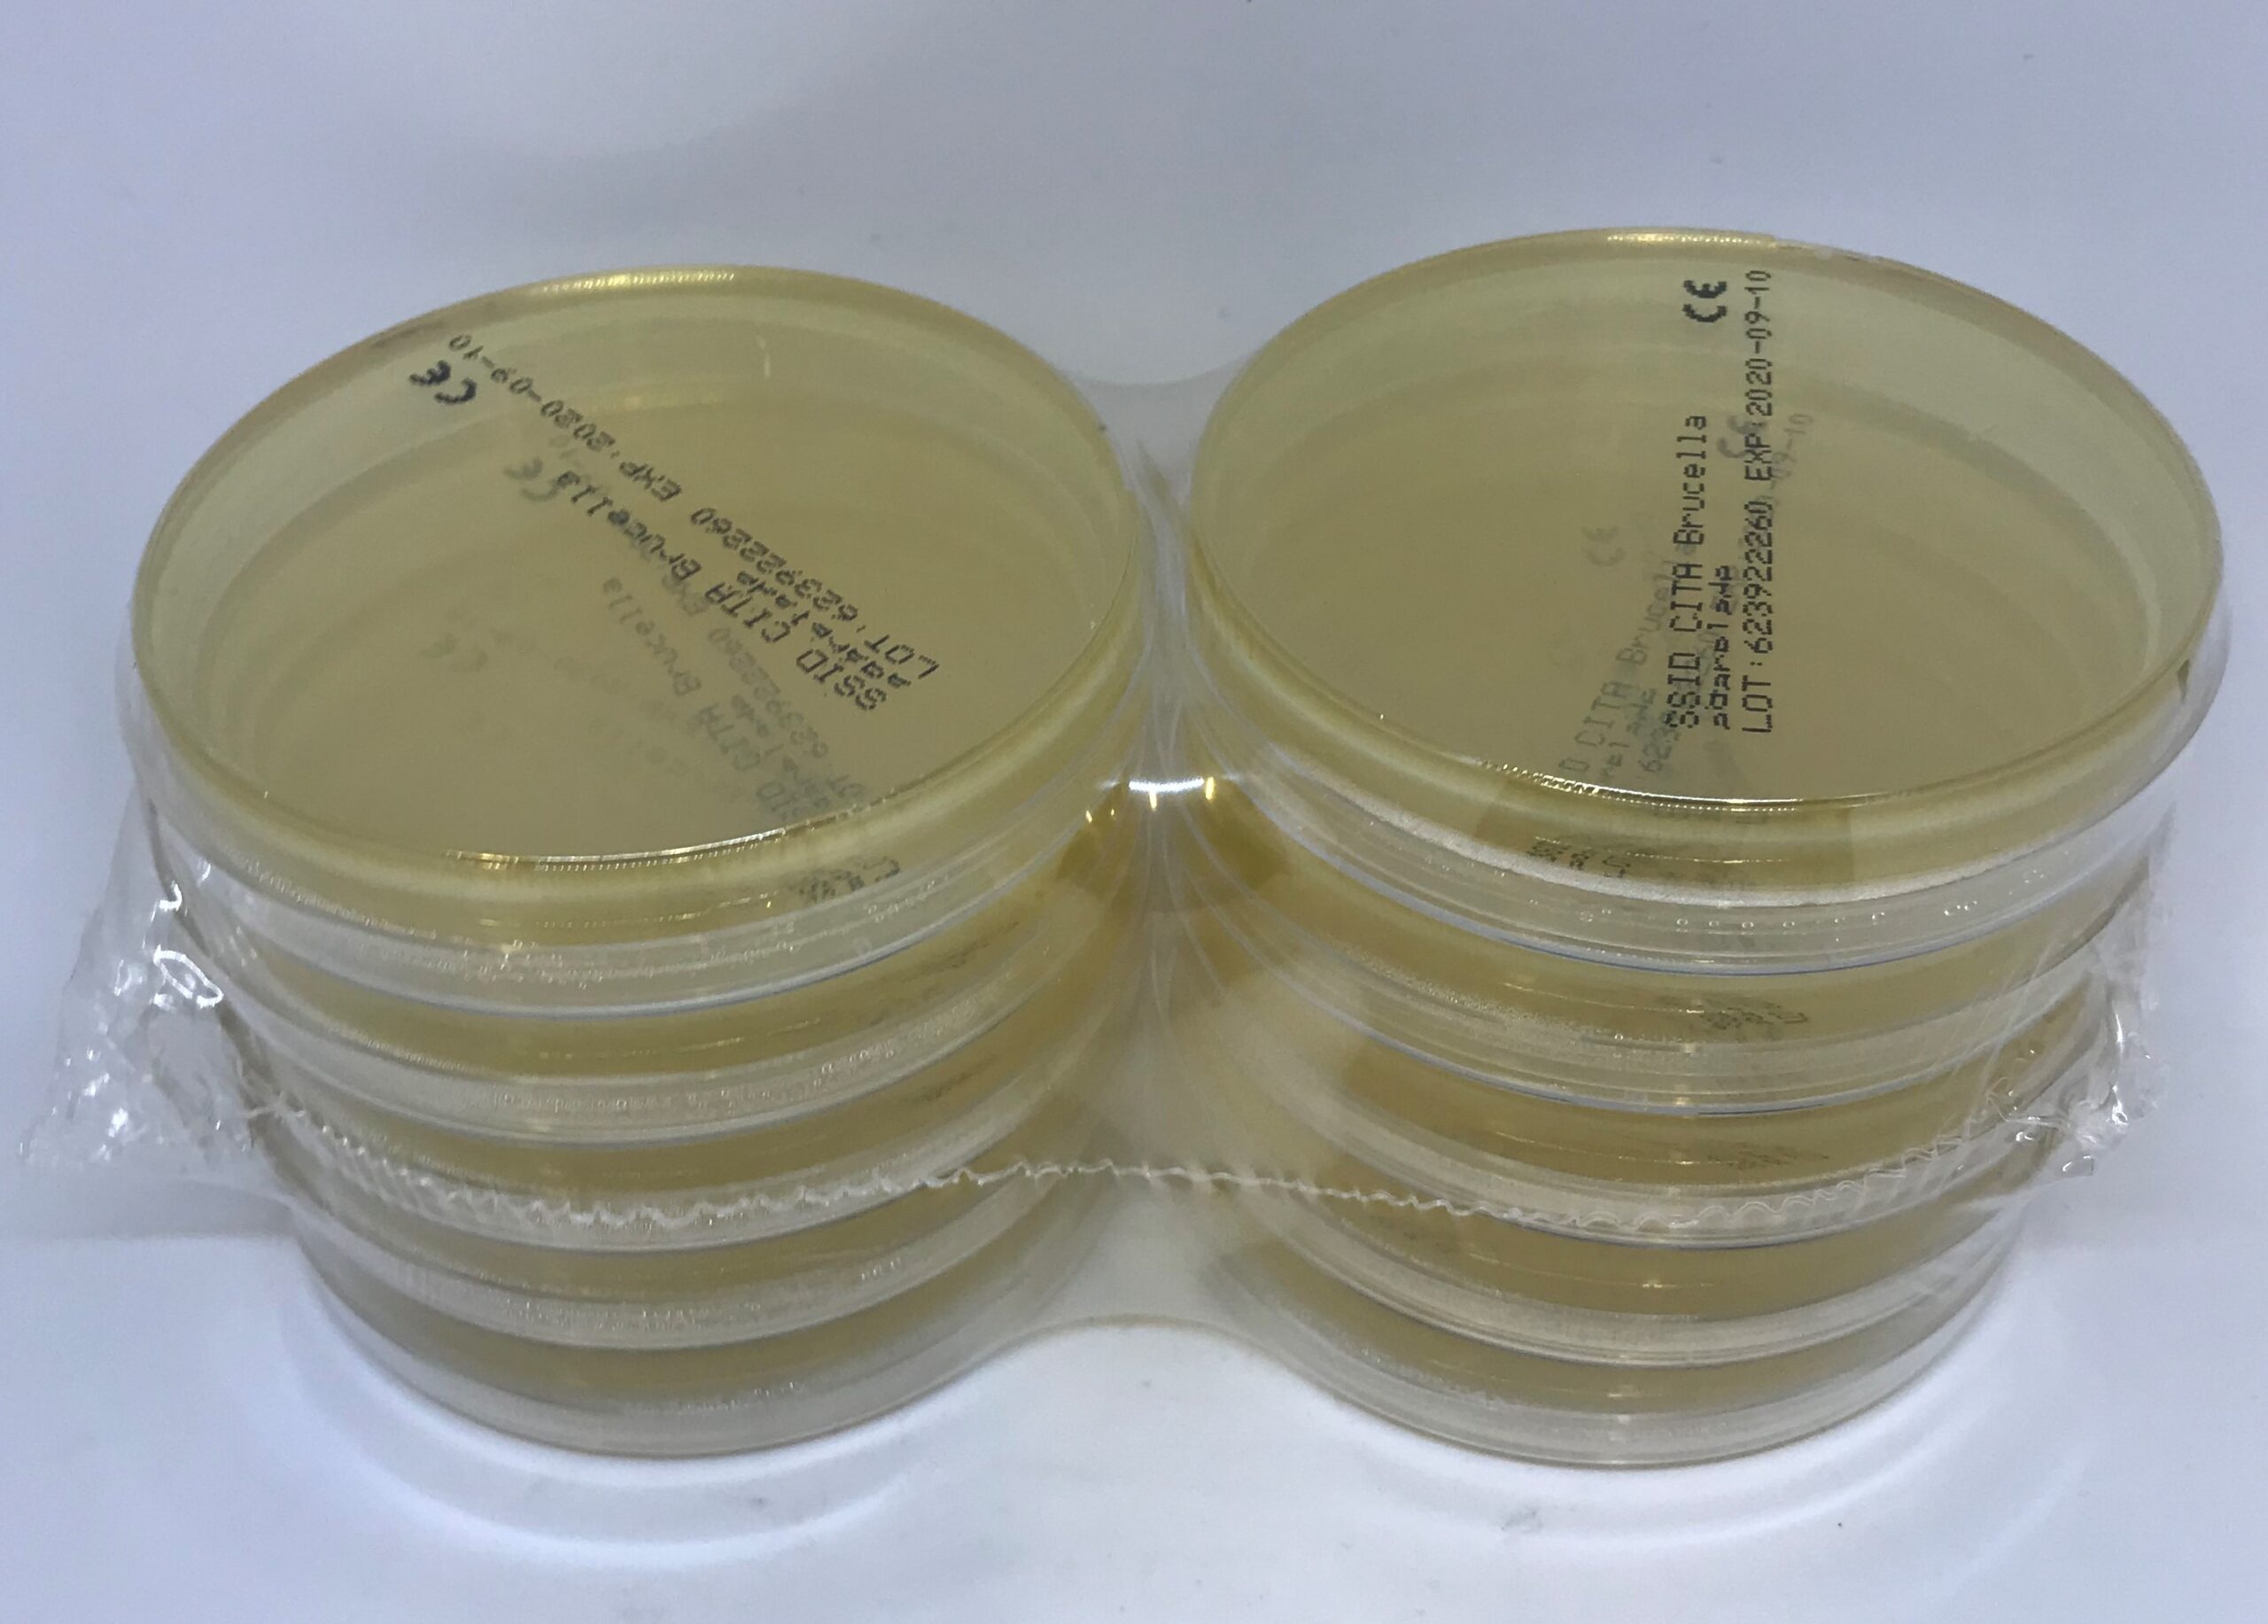
62392 CITA Brucella agarplade 9 cm 10 stk
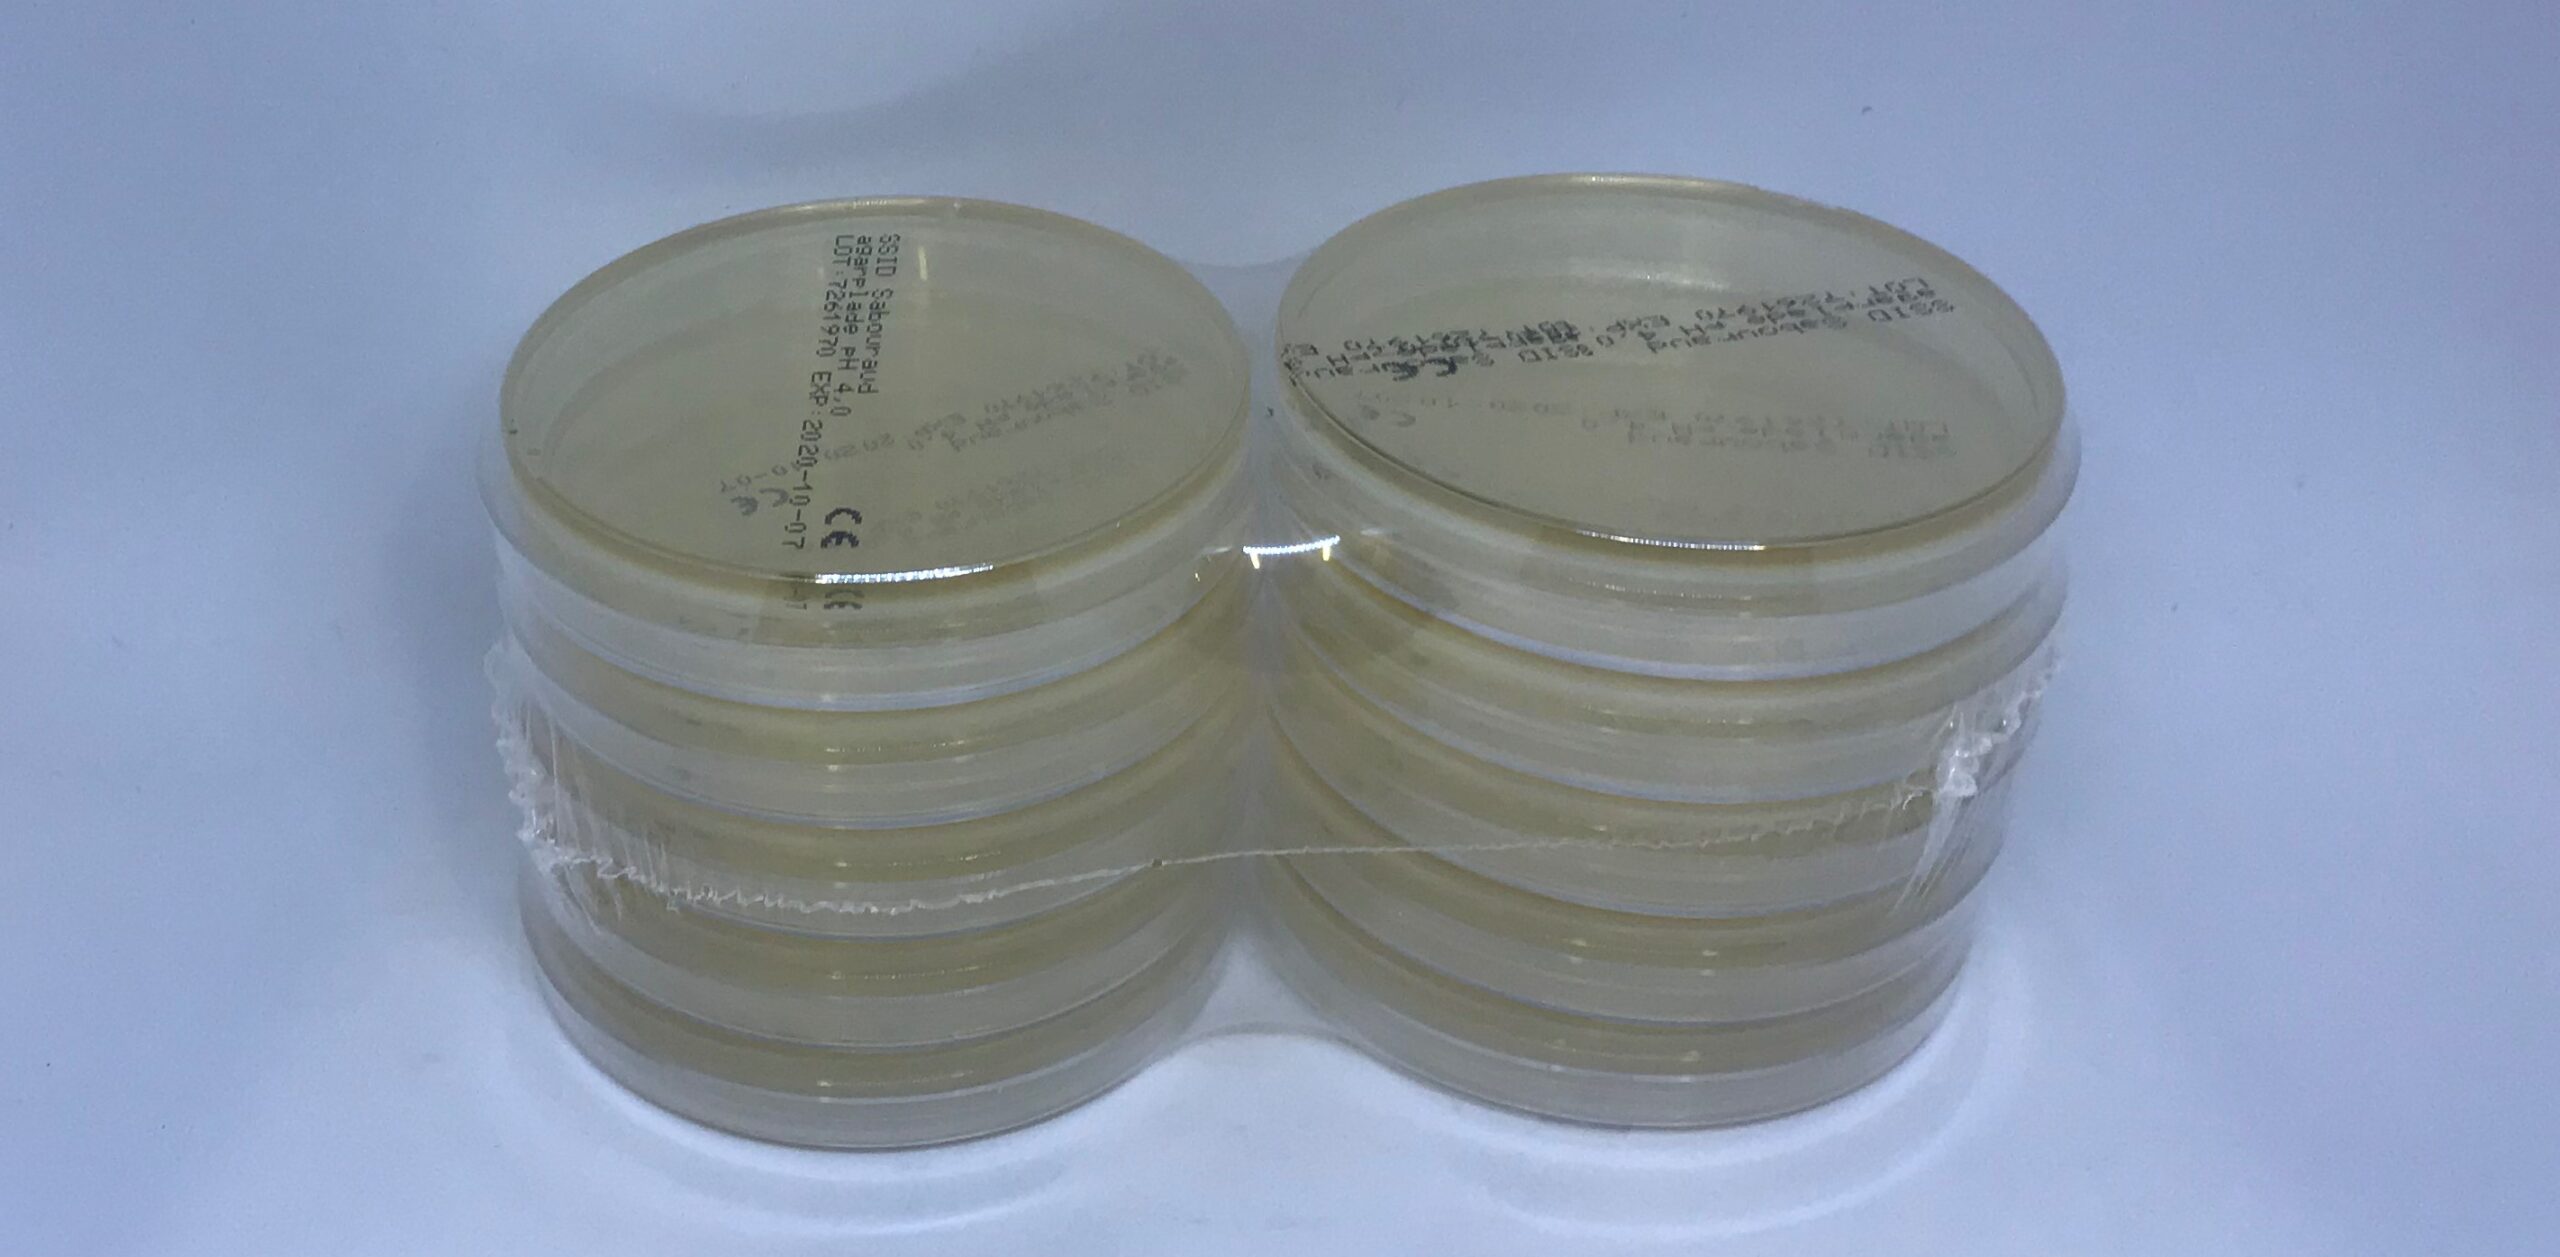
726 Sabouraud agarplade pH 4,0, 9 cm 10 stk
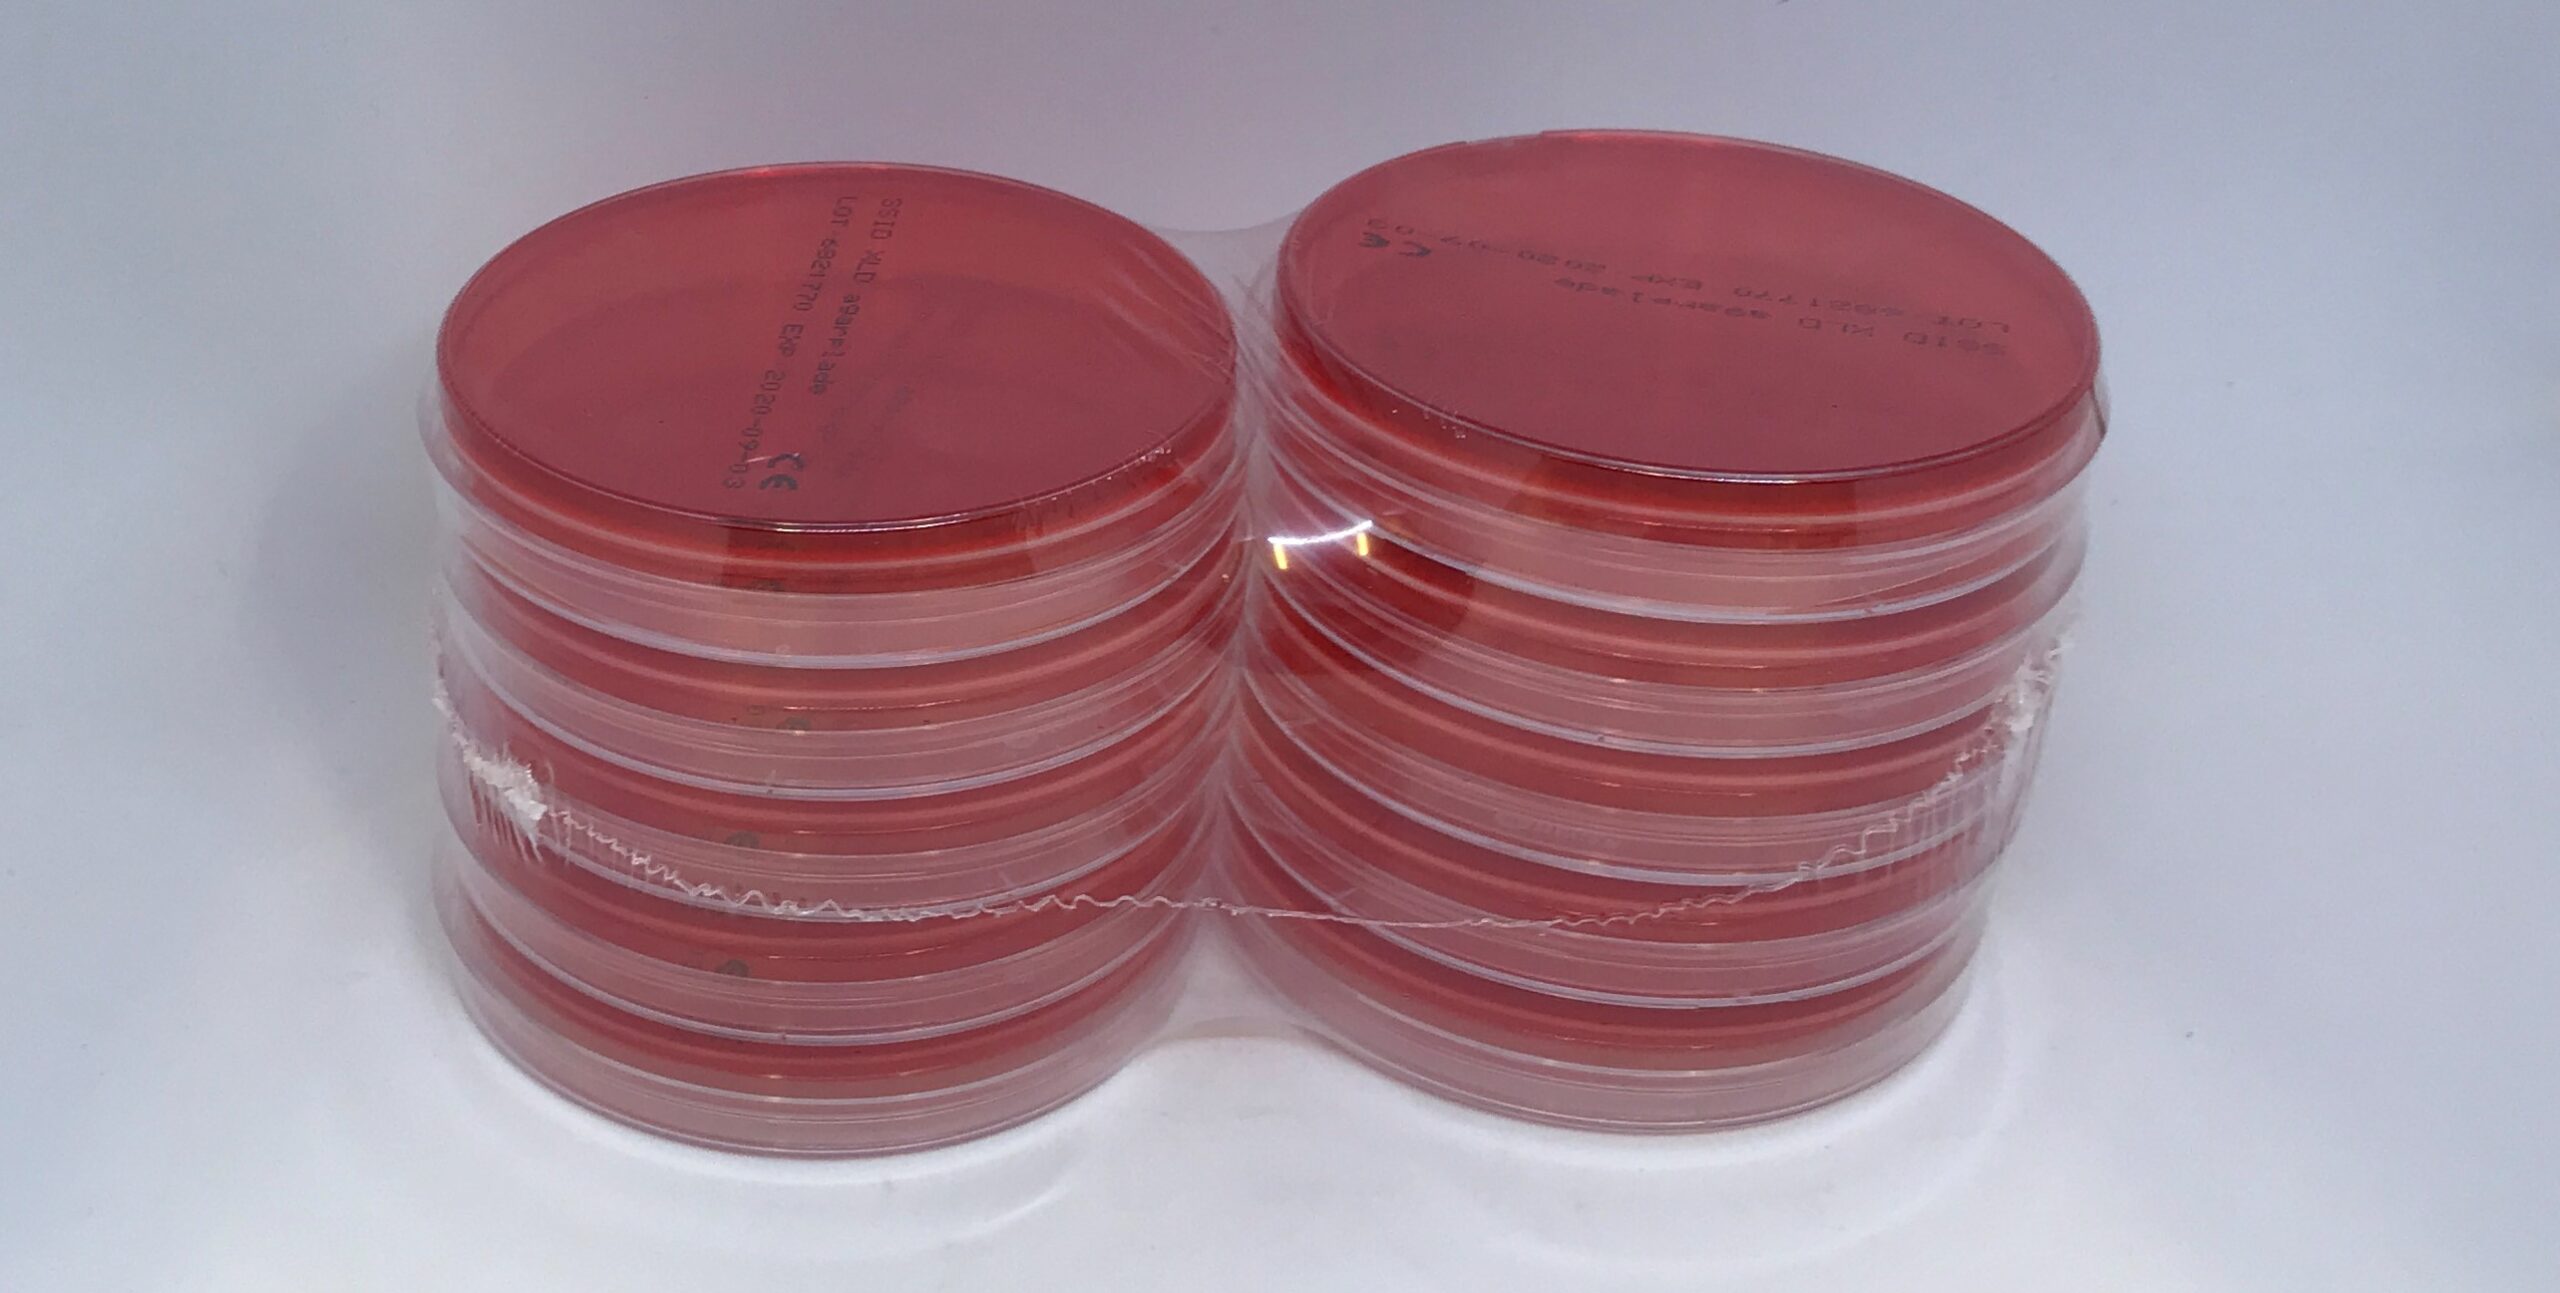
682 XLD agarplade, 9 cm 10 stk

Contact us
Agar Plates
We produce a broad variety of culturing media, from solid agar plates to liquids in tubes. The products are all of high quality and made with care and precision. And based on our more than 100 years of experience we are able to support your laboratory needs and questions.
Agar Plates 14 cm

MH agarplade m. 5% blod
Article nr.: 43656
Quantity: 10 pcs/pack
Make to order: Yes

Resistens agarplade
Article nr.: 784
Thickness: 6 mm
Quantity: 10 pcs/pack

SSI Diagnostica (rød) agarplade
Article nr.: 22880
Quantity: 10 pcs/pack
Agar Plates 9 cm
Agarplade
Article nr.: 672
Quantity: 10 pcs/pack
Agarplade m. RPMI og MOPS
Article nr.: 65506
Quantity: 10 pcs/pack

Anaerob agarplade
Article nr.: 673
Quantity:10 pcs/pack

Aztreonam agarplade
Article nr.: 80233
Quantity: 10 pcs/pack
Make to order: Yes

Blodagarplade 5%
Article nr.: 677
Quantity: 10 pcs/pack

Blodagarplade 5% m. esculin (SB1026)
Article nr.: 69049
Quantity: 10 pcs/pack
Make to order: Yes

Blodagarplade 5% m. esculin + 0,1IE/ML PEN(SB1126)
Article nr.: 69051
Quantity: 10 pcs/pack
Make to order: Yes

Blodagarplade 5% m. esculin+1,0 IE/mL PEN (SB1226)
Article nr.: 69053
Quantity: 10 pcs/pack
Make to order: Yes

Blodagarplade 5% m. esculin+1,0 IE/mL PEN (SB1226)
Article nr.: 69053
Quantity: 10 pcs/pack
Make to order: Yes

Blodagarplade 10%
Article nr.: 686
Quantity: 10 pcs/pack

Blå agarplade
Article nr.: 694
Quantity: 10 pcs/pack

Chokolade agarplade m. TMP
Article nr.: 707
Quantity: 10 pcs/pack

Chokolade agarplade
Article nr.: 700
Quantity: 10 pcs/pack

Chokolade agarpl. m. antibiotika
Article nr.: 703
Quantity: 10 pcs/pack

C-kalveblod agarplade
Article nr.: 18210
Quantity: 10 pcs/pack
Make to order: Yes

CIN agarplade
Article nr.: 44502
Quantity: 10 pcs/pack

Casein soya bean digest agar
Article nr.: 49612
Quantity: 10 pcs/pack
Make to order: Yes
CITA Brucella agarplade
Article nr.: 62392
Quantity: 10 pcs/pack
Make to order: Yes

CCDA agarplade
Article nr.: 18209
Quantity: 10 pcs/pack

Fuso agarplade
Article nr.: 74215
Quantity: 10 pcs/pack
Make to order: Yes

FAA agarplade m. 5% blod
Article nr.: 99439
Quantity: 10 pcs/pack

MacConkey agarplade
Article nr.: 712
Quantity: 10 pcs/pack
Make to order: Yes

PGUA agarplade
Article nr.: 722
Quantity: 10 pcs/pack
Make to order: Yes

SSI Diagnostica (rød) agarplade
Article nr.: 724
Quantity: 10 pcs/pack
Sabouraud agarplade pH 4,0
Article nr.: 726
Quantity: 10 pcs/pack

MRS agarplade
Article nr.: 29356
Quantity: 10 pcs/pack
Make to order: Yes

Sabouraud agarplade m. CYC og CHL
Article nr.: 729
Quantity: 10 pcs/pack

Sabouraud agarplade pH 5,6
Article nr.: 3566
Quantity: 10 pcs/pack
Make to order: Yes

R2A agarplade
Article nr.: 62440
Quantity: 10 pcs/pack
Make to order: Yes

Tellur agarplade
Article nr.: 728
Quantity: 10 pcs/pack

Long og Hammer agarplade
Article nr.: 70302
Quantity: 10 pcs/pack
Make to order: Yes

MH agarplade m. 5% blod og NAD
Article nr.: 77996
Quantity: 10 pcs/pack

TSA agarpl. m. 5 µg/mL aztreonam
Article nr.: 84852
Quantity: 10 pcs/pack
Make to order: Yes

Sabouraud-dextrose agarplade pH 5,6
Article nr.: 88543
Quantity: 10 pcs/pack

Tryptone soya agarplade
Article nr.: 91266
Quantity: 10 pcs/pack

UTI kromagarplade
Article nr.: 94712
Quantity: 10 pcs/pack

TYES agarplade
Article nr.: 95383
Quantity: 10 pcs/pack
Make to order: Yes

Potato Dextrose agar
Article nr.: 98731
Quantity: 10 pcs/pack
Make to order: Yes

TSA agarplade m. 5% fåreblod
Article nr.: 98763
Quantity: 10 pcs/pack
Make to order: Yes

TSA agarplade m. 5% kalveblod
Article nr.: 98802
Quantity: 10 pcs/pack
Make to order: Yes

LB agar
Article nr.: 98833
Quantity: 10 pcs/pack
Make to order: Yes

TBX agarplade
Article nr.: 99089
Quantity: 10 pcs/pack
Make to order: Yes

MYP agarplade
Article nr.: 99320
Quantity: 10 pcs/pack
Make to order: Yes

MH agarplade
Article nr.: 95383
Quantity: 10 pcs/pack
XLD agarplade
Article nr.: 682
Quantity: 10 pcs/pack
Make to order: Yes
Discover other culture media products
Get in touch
If you have any questions, comments, or collaboration inquiries, you are very welcome to reach out.
Please fill in the form and we will get back to you as soon as possible.